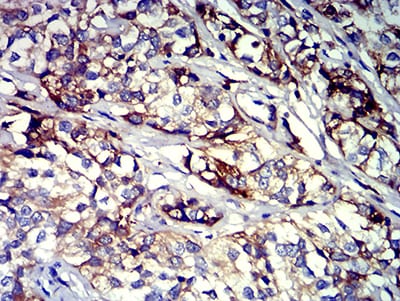
CD61

相关产品推荐更多 >
万千商家帮你免费找货
0 人在求购买到急需产品
- 详细信息
- 文献和实验
- 技术资料
- 免疫原:
peptide
- 亚型:
IgG1
- 形态:
Liquid
- 保存条件:
-20℃
- 克隆性:
mAb
- 适应物种:
Human
- 保质期:
1年
- 目录编号:
TD-31581
- 级别:
科研级
- 库存:
88
- 供应商:
武汉天德
- 宿主:
Mouse
- 应用范围:
FCM、ELISA、IHC
- 靶点:
详询
- 抗体英文名:
Mouse Monoclonal Antibody to CD61
- 抗体名:
CD61
- 规格:
100ul/50ul
| 规格: | 100ul | 产品价格: | ¥2180.0 |
|---|---|---|---|
| 规格: | 50ul | 产品价格: | ¥1280.0 |
Mouse Monoclonal Antibody to CD61
Description |
|||||||
| The ITGB3 protein product is the integrin beta chain beta 3. Integrins are integral cell-surface proteins composed of an alpha chain and a beta chain. A given chain may combine with multiple partners resulting in different integrins. Integrin beta 3 is found along with the alpha IIb chain in platelets. Integrins are known to participate in cell adhesion as well as cell-surface mediated signalling. | |||||||
Specification |
|||||||
| Aliases | ITGB3; GT; GP3A; BDPLT2; GPIIIa; BDPLT16 | ||||||
| Entrez GeneID | 3690 | ||||||
| Swissprot | P05106 | ||||||
| clone | 3E8A6 | ||||||
| WB Predicted band size | 87kDa | ||||||
| Host/Isotype | Mouse IgG1 | ||||||
| Antibody Type | Primary antibody | ||||||
| Storage | Store at 4°C short term. Aliquot and store at -20°C long term. Avoid freeze/thaw cycles. | ||||||
| Species Reactivity | Human | ||||||
| Immunogen | Purified recombinant fragment of human CD61 (AA: extra 27-179) expressed in E. Coli. | ||||||
| Formulation | Purified antibody in PBS with 0.05% sodium azide | ||||||
Application |
|||||||
| IHC | 1/200 - 1/1000 | ||||||
| FCM | 1/200 - 1/400 | ||||||
| ELISA | 1/10000 | ||||||
Product Image
|
|||||||
风险提示:丁香通仅作为第三方平台,为商家信息发布提供平台空间。用户咨询产品时请注意保护个人信息及财产安全,合理判断,谨慎选购商品,商家和用户对交易行为负责。对于医疗器械类产品,请先查证核实企业经营资质和医疗器械产品注册证情况。
 文献和实验
文献和实验CD61 分子 CD61 常用单克隆抗体或代号: Y2/51,CLB- thromb/1;(VNR- b 链,integrin b 3) 主要表达细胞: Pt,Meg [Pt] 分子质量(kDa)和结构: gp105,血小板GPⅢa,与CD51组成VNR,与CD41组成a Ⅱbb 3 功 能: 血小板凝集和活化 CD61 Aka platelet glycoprotein IIb
人血小板膜糖蛋白IIbIIIa(GP-IIbIIIa/CD41+CD61)抗体
人血小板膜糖蛋白IIbIIIa(GP-IIbIIIa/CD41+CD61) 抗体 酶联免疫分析试剂盒使用说明书 本试剂仅供研究使用 目的:本试剂盒用于测定人血清,血浆及相关液体样本中血小板膜糖蛋白IIbIIIa(GP-IIbIIIa/CD41+CD61) 抗体 的含量。 实验原理: 本试剂盒应用双抗原夹心法测定标本中人血小板膜糖蛋白 IIbIIIa(GP-IIbIIIa/CD41+CD61) 抗体
的优点1、全血中血小板更接近生理状态。2、操作简便,减少由于操作造成的血小板状态改变(如血小板活化试验)。 3、同时检测血小板的多个标志物,结合FSC和SSC,评估多个参数,进行定量分析。 4、多采用血小板特异抗体CD41或CD61画门,找出血小板,避免杂质碎片的干扰。 5、检测血小板亚群灵敏度高。6、用血量少。 7、无放射性污染。四、全血样本的制备1、抽取抗凝全血:检测血小板功能时,应使用标准化的抽血规程;做血小板活化试验时,应尽量减少人为造成的血小板活化。 2、Falcon管中加取全血和适量
 技术资料
技术资料暂无技术资料 索取技术资料